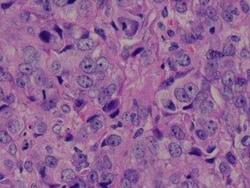
Novus Biologicals Human Breast Tissue Lysate (Adult Tumor) 0.1 mg | Buy Online | Novus Biologicals&trade; | Fisher Scientific

missing translation for 'onlineSavingsMsg'
Learn More
Learn More
Novus Biologicals™ Human Breast Tissue Lysate (Adult Tumor)
Shop All Bio Techne Products
Click to view available options
Quantity:
0.1 mg
Unit Size:
0.10mg
Specifications
Specifications
| Preparation Method | These lysates are proteomic discovery tools.Researchers should validate and optimize for individual use. Potential applications MAY include WB, immunoprecipitation, protein-protein interactions, ligand binding, ELISA. Note: For use in 1D and 2D gel electrophoresis, the addition of a denaturing gel loading buffer with reducing agents may be required. |
| Quantity | 0.1 mg |
| Content And Storage | Store at -20°C short term. Aliquot and store at -70°C long term. Avoid freeze-thaw cycles. |
| Target | Breast |
Product Content Correction
Your input is important to us. Please complete this form to provide feedback related to the content on this product.
Product Title
Spot an opportunity for improvement?Share a Content Correction